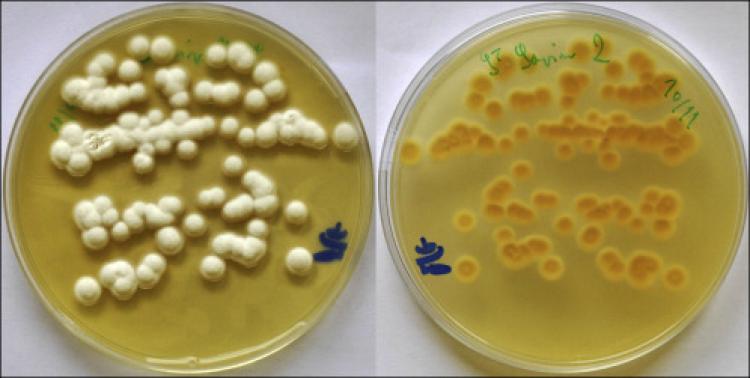

Plastik tullantılara Yer kürəsində insanların mövcud olduqları bütün yerlərdə rast gəlmək olar. Təkrar emalı qəliz olan bu material uzun illər ərzində təbiətdə qalacaq. Sakit okeanda olan plastik tullantılar hətta öz biosferlərini də yaratmağa başlayıblar və həmin tullantılarda sahilyanı canlı orqanizmlər yaşayırlar. Məlum olub ki, Avstraliyadan olan alimlər plastik materialları parçalamağa qadir iki növ torpaq göbələyi aşkar ediblər. Sidney Universitetinin mütəxəssisləri aparmış olduqları təcrübə çərçivəsində Aspergillus terreus və Engyodontium album adlı göbələklərin polipropileni (təkrar emalı qəliz olan plastik material növü) parçaladıqlarını təsdiqləyiblər. Məlumata əsasən bütün plastik tullantıların 25%-i məhz polipropilenin payına düşür. Söhbət, qida qablarından, paltarlar üçün asılqanlardan və s.əşyalardan gedir.
Sənaye səviyyəsində təkrar emal prosesinə isə istehsal edilmiş polipropilenin yalnız 1%-i çatır. Bu isə sözügedən plastik material növünün iri həcmdə tullantılara sahib olduğundan xəbər verir. Alimlər təyin ediblər ki, plastik materiallara öncədən ultrabənövşəyi şüalar vasitəsilə təsir göstərdikdə və onları qızdırdıqda aşkar edilmiş torpaq göbələkləri polipropileni daha aktiv şəkildə parçalayırlar. Təbiətdə Günəşdən gələn ultrabənövşəyi şüalar və istilik var. Buna görə də sözügedən torpaq göbələkləri təbii mühitdə polipropileni rahat şəkildə parçalaya bilərlər. Sözügedən təsirlərə məruz qalmış plastik material laboratoriya şəraitində Aspergillus terreus və Engyodontium album adlı göbələklər tərəfindən 30 gün ərzində 21% parçalanıb. 90 gün ərzində isə göbələklər plastik materialın 25-27%-ni parçalayıblar.
- Baxış: 524